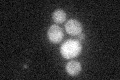
YDR252W
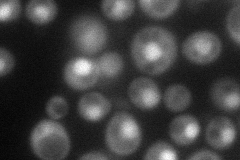
YDR252W
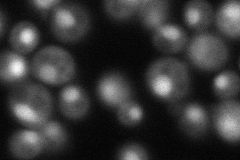
YDR252W
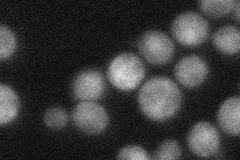
YDR252W
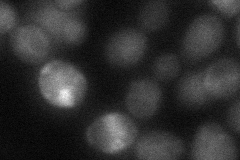
YDR252W

View description
Beta3 subunit of the heterotrimeric nascent polypeptide-associated complex which binds ribosomes via its beta-subunits in close proximity to nascent polypeptides; interacts with Caf130p of the CCR4-NOT complex; similar to human BTF3
Localization:
Intensity:
Fold change:
Significance:
-
C’ GFP library in SD
cytosol26.75 -
N' NOP1pr-GFP in SD
nucleus69.1563 -
N' TEF2pr-mCherry in SD
nucleus63.1777 -
N' NATIVEpr-GFP in SD
cytosol33.7526 -
N' TEF2pr-VC and Cyto-VN in SD
cytosol,nucleus37.4058 -
C’ GFP library in SD+DTT

cytosol22.780.85No -
C’ GFP library in SD+H2O2

cytosol22.040.82No -
C’ GFP library in Starvation Media

cytosol18.110.67No -
C’ GFP library on the background of Pup2-DaMP

cytosol -
C’ GFP library on the background of CCT mutant

cytosol20.93210.782281No
